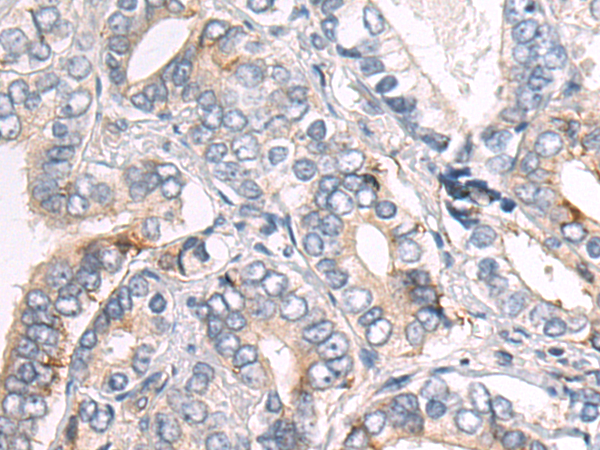
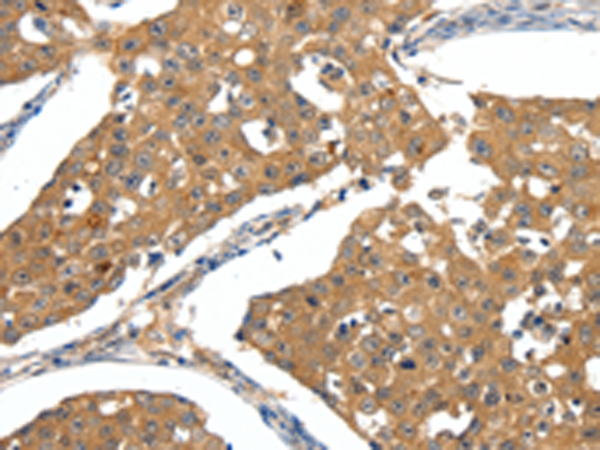
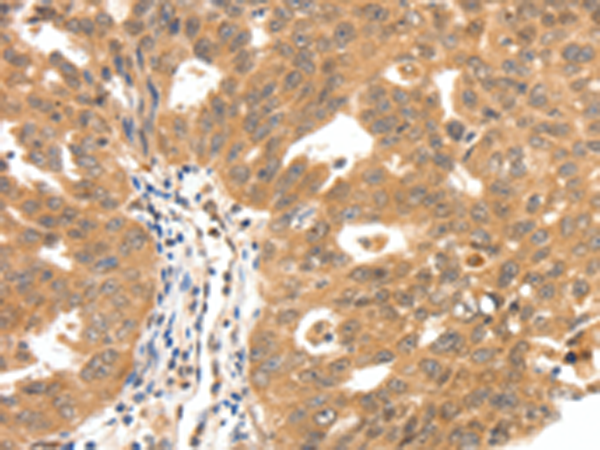

-
分类: 科研抗体货号: P04369别名: SYLD应用: WB,IHC反应种属: Human, Mouse, Rat
-
分类: 科研抗体货号: P04368别名: NEP, SFE, CD10, CALLA应用: WB,IHC反应种属: Human, Mouse, Rat
-
分类: 科研抗体货号: P04395别名: NPY2-R应用: IHC反应种属: Human, Mouse
-
分类: 科研抗体货号: P04364别名: CD146; MUC18; HEMCAM; METCAM; MelCAM应用: WB,IHC反应种属: Human
-
分类: 科研抗体货号: P04446别名: IRH; PBSF; SDF1; TLSF; SDF1A; SDF1B; TPAR1; SCYB12应用: IHC反应种属: Human, Mouse
-
分类: 科研抗体货号: P04393别名: INT3应用: WB,IHC反应种属: Human
-
分类: 科研抗体货号: P04363别名: CA125应用: IHC反应种属: Human
-
分类: 科研抗体货号: P04442别名: HB1; HB2; HH1; IVF; VF1; HBBD; ICCD; LQT3; SSS1; CDCD2; CMD1E; CMPD2; PFHB1; Nav1.5应用: IHC反应种属: Human, Mouse, Rat
-
分类: 科研抗体货号: P04389别名: ASY, NSP, NOGO, NOGOC, RTN-X, NOGO-A, NSP-CL, Nogo-B, Nogo-C, RTN4-A, RTN4-C, RTN4-B1, RTN4-B2, NI220/250, Nbla00271, Nbla10545应用: IHC反应种属: Human, Mouse, Rat
-
分类: 科研抗体货号: P04360别名: MUC3, MUC-3A应用: IHC反应种属: Human

鄂公网安备42018502007531号
鄂公网安备42018502007531号

